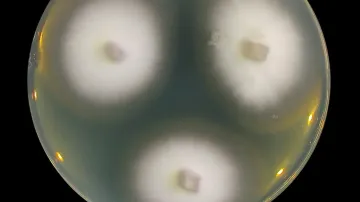
Houba šířící se v Íránu

Houbové sítě si mezi sebou vyměňují spoustu informací. V novém experimentu japonských mykologů se ukázalo, že si předávají odlišné informace v závislosti na tom, jestli na ně dopadají kapky vody nebo moči. A tato komunikace je opravdu bleskurychlá.
Sběrače hub zajímá hlavně to, co z nich vykukuje nad povrchem – tedy chutné klobouky a elegantní nožky, ať už štíhlé, nebo buclaté. Ale u hub platí, stejně jako u ledovců, že to důležité se skrývá pod povrchem. Právě tam, v půdě, se totiž skrývají takzvané myceliální sítě, obří a nesmírně komplexní opravdová těla hub, která slouží k jejich výživě – ale také ke komunikaci.
Houby si pomocí těchto vláken vyměňují informace o vnějších podnětech, mnohdy i na základě nedostatečných dat. Posílají do organismu vše, co se k nim dostane. Proto tato komunikace může připomínat lidské drby a pomluvy.
Houbové podzemní struktury jsou ale tak obří a propletené, že se jen nesmírně špatně studují, proto se toho o nich dodnes ví tak málo. Poznání se pokusili rozšířit vědci z japonské Tohoku University.
Experiment
Výzkum vedl Jú Fukasawa, což je jeden z nejslavnějších světových expertů na houby. Jeho tým sledoval komunikaci u 37 hub, konkrétně reakce na kapičky vody nebo močoviny, které mykologové houbám dodávali.
Proč voda a močovina? Zkoumané houby totiž patřily k takzvaným amoniakovým houbám, které se aktivují, když je v půdě dostatek amoniaku. Močovina, která je v moči obsažená, s amoniakem chemicky souvisí, takže může podporovat jejich růst. Podobně klíčový je, jak ví každý houbař, také vliv vody.
Když tento druh zaznamená jakoukoliv chemickou zprávu, že by se někde v okolí mohla vyskytovat močovina, zbystří. Tohle přesně naznačovala hypotéza, ale jak se houby zachovaly doopravdy?
Fukasawa aplikoval buď normální kohoutkovou vodu, nebo moč na půdu kolem hub pěstovaných lokálně ve městě Kami v prefektuře Mijagi, aby zjistil jejich reakci.
Po analýze dat o elektrické dynamice všech 37 hub se ukázalo, že výsledky se lišily v závislosti na tom, jestli houby přijaly vodu z kohoutku, anebo moč, ale také podle toho, jestli byly tyto tekutiny aplikované na koncentrovanou oblast, nebo na rozsáhlou plochu. Roli hrála také prostorová a genetická vzdálenost mezi houbami.
V rámci experimentu se každý den střídalo nanášení vody a moči. Když autoři nanesli vodu kolem jedné konkrétní houby, zvýšil se tok informací. Ve dnech, kdy byla nanesena moč, ale došlo k poklesu. Při nanášení vody na rozsáhlejší plochu se ale tok informací snížil. Vždy přitom platilo, že se informace šířily mezi jednotlivými houbami nesmírně rychle – v podstatě se o moči nebo vodě dozvěděly okamžitě.
„Je fascinující přemýšlet o tom, proč houby komunikují právě tímto způsobem,“ říká Fukasawa. „Například pokud se voda dostane ke všem houbám, nemusí být nutné sdílet informace, protože celá síť už ví, co se děje. To by mohlo být důvodem, proč v této situaci tok informací poklesl.“
Tyto výsledky naznačují, že lesní houby mohou flexibilně měnit svůj tok elektrických informací v reakci na různé rušivé vlivy. Tyto poznatky by mohly pomoci při řešení záhad obklopujících elektrickou komunikaci u hub, zdůrazňují autoři.